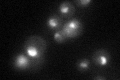
YDR457W
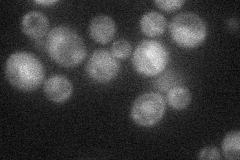
YDR457W

View description
E3 ubiquitin ligase of the hect-domain class; has a role in mRNA export from the nucleus and may regulate transcriptional coactivators; involved in degradation of excess histones
Localization:
Intensity:
Fold change:
Significance:
-
C’ GFP library in SD
nucleolus34.84 -
N' NOP1pr-GFP in SD
cytosol26.6002 -
N' TEF2pr-mCherry in SD

below threshold7.58658 -
N' NATIVEpr-GFP in SD

cytosol23.5925 -
N' TEF2pr-VC and Cyto-VN in SD

below threshold25.8543 -
C’ GFP library in SD+DTT

nucleolus29.290.84No -
C’ GFP library in SD+H2O2

nucleolus38.151.09No -
C’ GFP library in Starvation Media

nucleolus22.320.64Yes -
C’ GFP library on the background of Pup2-DaMP

nucleolus -
C’ GFP library on the background of CCT mutant

nucleolus36.92521.05966No
